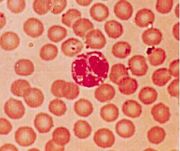

File list
This special page shows all uploaded files.
| Date | Name | Thumbnail | Size | User | Description | Versions |
|---|---|---|---|---|---|---|
| 12:59, 30 August 2007 | Cytoplasmic dynein.PNG (file) |  |
8 KB | Alexm1983 | 1 | |
| 13:51, 30 August 2007 | Wallerian.jpg (file) |  |
74 KB | Alexm1983 | 1 | |
| 14:51, 30 August 2007 | Myelination.gif (file) |  |
34 KB | Alexm1983 | 1 | |
| 22:30, 30 August 2007 | 001.JPG (file) |  |
15 KB | Eabachynsky | 1 | |
| 23:12, 30 August 2007 | 002.JPG (file) |  |
29 KB | Eabachynsky | 1 | |
| 23:12, 30 August 2007 | 03 - classic lobule.JPG (file) |  |
19 KB | Eabachynsky | 1 | |
| 23:13, 30 August 2007 | 04 - zones.JPG (file) |  |
10 KB | Eabachynsky | 1 | |
| 23:13, 30 August 2007 | 05 - hepatocyte.JPG (file) |  |
42 KB | Eabachynsky | 1 | |
| 23:13, 30 August 2007 | 06 - phagocytic cells (Kuppfer).JPG (file) |  |
14 KB | Eabachynsky | 1 | |
| 23:13, 30 August 2007 | 07 - Ito cells - lipocytes storing Vitamin A.JPG (file) |  |
11 KB | Eabachynsky | 1 | |
| 07:10, 31 August 2007 | Normal adrenal cortex.jpg (file) |  |
182 KB | Kjr35 | 1 | |
| 07:12, 31 August 2007 | Adrenal atrophy.jpg (file) |  |
160 KB | Kjr35 | 1 | |
| 07:14, 31 August 2007 | Adrenal necrosis.jpg (file) |  |
146 KB | Kjr35 | 1 | |
| 07:17, 31 August 2007 | Adrenal necrosis2.jpg (file) |  |
101 KB | Kjr35 | 1 | |
| 07:18, 31 August 2007 | Cushings alopecia.jpg (file) |  |
158 KB | Kjr35 | 1 | |
| 07:23, 31 August 2007 | Chromophobe adenoma.jpg (file) |  |
84 KB | Kjr35 | 1 | |
| 07:25, 31 August 2007 | Nodular hyperplasia.jpg (file) |  |
110 KB | Kjr35 | 1 | |
| 07:26, 31 August 2007 | Adrenal neoplasia.jpg (file) |  |
37 KB | Kjr35 | 1 | |
| 07:27, 31 August 2007 | Mitotane therapy.jpg (file) |  |
70 KB | Kjr35 | 1 | |
| 07:28, 31 August 2007 | Myxoedema.jpg (file) |  |
150 KB | Kjr35 | 1 | |
| 07:35, 31 August 2007 | Flame follicles.jpg (file) |  |
140 KB | Kjr35 | 1 | |
| 09:14, 31 August 2007 | Serous fluid vesicle.jpg (file) |  |
43 KB | Lizzies | Histological appearance of a vesicle in the skin, containting serous exudate. Pending permission from Brian Smyth. | 1 |
| 09:20, 31 August 2007 | Acute fibrinous bronchopneumonia.jpg (file) |  |
47 KB | Lizzies | Gross appearance on acute fibrinous bronchopneumonia in the ox, caused by ''Pasteurella sp.''. Note the septae are distended with fibrinous exudate. Pending permission from Brian Smyth. | 1 |
| 09:23, 31 August 2007 | Acute abscess.jpg (file) |  |
23 KB | Lizzies | Cross section through an acute abscess. Pending permission from Brian Smyth. | 1 |
| 09:28, 31 August 2007 | Neutrophils.jpg (file) |  |
13 KB | Lizzies | Neutrophils (H&E). Pending permission from Brian Smyth. | 1 |
| 09:28, 31 August 2007 | Eosinophils.jpg (file) | |
17 KB | Lizzies | Eosinophils (H&E). Pending permission from Brian Smyth. | 1 |
| 09:29, 31 August 2007 | Mast cells.jpg (file) |  |
37 KB | Lizzies | Mast cells. Pending permission from Brian Smyth. | 1 |
| 09:32, 31 August 2007 | Lymphocytes and plasma cell.jpg (file) |  |
21 KB | Lizzies | Note the 4 lymphocytes on the right hand side, and the plasma cell with the perinuclear halo. Pending permission from Brian Smyth. | 1 |
| 09:34, 31 August 2007 | Macrophages.jpg (file) |  |
15 KB | Lizzies | Macrophages. Pending permission from Brian Smyth. | 1 |
| 09:37, 31 August 2007 | Langhans giant cell.jpg (file) |  |
54 KB | Lizzies | Langhans giant cell. Pending permission from Brian Smyth. | 1 |
| 09:42, 31 August 2007 | Lumpy jaw presentation.jpg (file) |  |
41 KB | Lizzies | Cow showing actinomycosis of the jaw (Lumpy Jaw). Note the mandibular swelling. Pending permission from Brian Smyth. | 1 |
| 09:43, 31 August 2007 | Lumpy jaw mandible.jpg (file) |  |
17 KB | Lizzies | "Honeycomb" appearance of mandible, following actinomycosis (Lumpy Jaw). Pending permission from Brian Smyth. | 1 |
| 09:45, 31 August 2007 | Lumpy jaw histology.jpg (file) |  |
26 KB | Lizzies | Structure of a granuloma in Lumpy Jaw (actinomycosis). Note the central core of bacteria, surrounded by "clubs", followed by a layer of inflammatory cells (neutrophils and macrophages). Pending permission from Brian Smyth. | 1 |
| 09:48, 31 August 2007 | Tuberculous granulomas.jpg (file) |  |
20 KB | Lizzies | Gross appearance of tuberculous granulomas in the lymph node of the ox. These granulomas show a degree of calcification. Pending permission fromo Brian Smyth. | 1 |
| 09:51, 31 August 2007 | Perivascular cuffing.jpg (file) |  |
44 KB | Lizzies | Lymphocytic perivascular cuffing in louping ill in the sheep. Pending permission from Brian Smyth. | 1 |
| 09:54, 31 August 2007 | Lymphoid follicle lung.jpg (file) |  |
64 KB | Lizzies | Lymphoid follicle in the lung. Has developed following extensive lymphocytic infiltration. Pending permission from Brian Smyth. | 1 |
| 10:09, 31 August 2007 | Pyometra.jpg (file) |  |
23 KB | Lizzies | Pyometra - outside surface of the uterus. Pending permission from Brian Smyth. | 1 |
| 10:11, 31 August 2007 | Bronchopneumonia ox.jpg (file) |  |
40 KB | Lizzies | Bronchonpneumonia in the ox (gross). Pending permission from Brian Smyth. | 1 |
| 10:14, 31 August 2007 | Fog fever.jpg (file) |  |
33 KB | Lizzies | Gross appearance of "Fog Fever" in the ox. Pending permission from Brian Smyth. | 1 |
| 10:20, 31 August 2007 | Lungworm.jpg (file) |  |
24 KB | Lizzies | ''Dictyocaulus vivipara'' in the lung of the ox. Causes verminous pneumonia. Pending permission from Brian Smyth. | 1 |
| 10:25, 31 August 2007 | Johnes disease comparative.jpg (file) |  |
23 KB | Lizzies | Comparative gross appearance of Johne's Disease in the ox. The intestine on the right is diseased, whereas that on the left is normal. Pending permission from Brian Smyth. | 1 |
| 10:31, 31 August 2007 | Cirrhosis pig.jpg (file) |  |
25 KB | Lizzies | Cirrhosis, due to chronic liver damage in the pig. Pending permission fro Brian Smyth. | 1 |
| 10:44, 31 August 2007 | Granultion tissue histology.jpg (file) |  |
74 KB | Lizzies | Histological appearance of maturing granulation tissue. Courtesty of BioMed Archive. | 1 |
| 10:46, 31 August 2007 | Fracture callus.jpg (file) |  |
72 KB | Lizzies | Fracture callus. Courtesy of BioMed Archive. | 1 |
| 10:48, 31 August 2007 | Vegetative endocarditis.jpg (file) |  |
83 KB | Kjr35 | 1 | |
| 10:48, 31 August 2007 | Fracture repair.jpg (file) |  |
70 KB | Lizzies | Histological appearance of a repairing fracture. Courtesy of BioMed Archive. | 1 |
| 10:51, 31 August 2007 | Scar tissue.jpg (file) |  |
64 KB | Lizzies | Histological appearance of scar tissue. Courtesy of BioMed Archive. | 1 |
| 10:51, 31 August 2007 | Dilated left atrium.jpg (file) |  |
56 KB | Kjr35 | 1 | |
| 10:56, 31 August 2007 | Thrombosis dog nose.jpg (file) |  |
124 KB | Kjr35 | 1 | |
| 10:56, 31 August 2007 | Thrombosis dog nose 2.jpg (file) |  |
125 KB | Kjr35 | 1 |